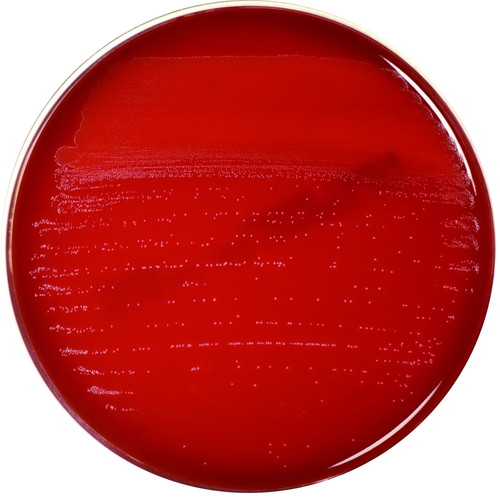

現在 ヴィン ディーゼル 筋肉 (363 無料画像)
写真 『リディック』シリーズ、ヴィン・ディーゼルがスピンオフドラマを製作 - 海外ドラマ - ニュース クランクイン。
ワイルド・スピード』ヴィン・ディーゼルとタイリース・ギブソンがアツいコメント ─ 「兄弟に感謝」「さあ行くぜ」THE RIVER。
イタすぎるセレブ達 ヴィン・ディーゼル、たるんたボディを激写され“ある行動”に。Techinsight テックインサイト 海外セレブ、国内エンタメのオンリーワンをお届けするニュースサイト。
ワイルド・スピードにおけるヴィン・ディーゼルの進化 : r fastandfurious。
映画俳優兼監督のヴィンディーゼルの筋肉が凄い!トレーニング方法を紹介! - Fitmo。
Transformación física de Vin Diesel: 270 lbs de músculo。
画像 ヴィンディーゼルの筋肉!身長・体脂肪率〜筋トレ&食事まで紹介!ボディメイクブログSlope スロープ モテる男への坂道を登るメディア。
ヴィン・ディーゼル主演『ワイルド・スピード』シリーズ第9弾『ワイルド・スピード ジェットブレイク』最新劇中ショット2枚公開!! –アクション・スター・ネットワーク。
トリプルX』シリーズ3作目にはヴィン・ディーゼル復帰か?シネマトゥデイ。
ヴィンディーゼル ヴィン・ディーゼルの年齢身長出演作プロフィール&結婚や子供は?かっこいい。
写真 『トリプルX』ヴィン・ディーゼル、世界レベルの美女に囲まれニンマリ? - 映画 - ニュース クランクイン。
ワイルドスピード ドミニク トレット カスタム 1 6 ワイルドスピード 1 6 ドミニク ヴィン・ディーゼル ホット。
ヴィン・ディーゼル、元アシスタントから性的暴行で提訴される - THR Japan。
ヴィンディーゼルの筋肉と筋トレメニューSILVER GYM シルバージム。
ヴィンディーゼル着用風 ノースリーブ インナー - 映画レプリカ・映画革ジャン通販店のHOLLYWOOD VILLAGE。
画像 ヴィンディーゼルの筋肉!身長・体脂肪率〜筋トレ&食事まで紹介!ボディメイクブログSlope スロープ モテる男への坂道を登るメディア。
ワイルド・スピード』ヴィン・ディーゼルの「40年前の姿」に時代を感じるフロントロウ。
ワイルド・スピード』9作目の撮影がついに開始したことをヴィン・ディーゼルが報告!!!!ぶっちゃけシネマ人生一直線!❁。
映画界最強 「ワイスピ」シリーズを彩ってきた俳優たち!1 2- SCREEN ONLINE スクリーンオンライン。
ヴィン・ディーゼル、LA山火事を受け『ワイスピ』新作をロサンゼルスで撮影と約束 - セレブ&ゴシップ - ニュース クランクイン。
世界的映画俳優 元アシスタントから性的暴行で訴えられる 海外スターバックナンバー 芸能 デイリースポーツ online。
Vin DieselKnappe mannen, Mooie mannen, Filmsterren。
ヴィン・ディーゼルが白ひげ役 : r OnePieceLiveAction。
ゆー∞→ 2025年、2月 UVERworld 仙台GIGS 2days on X: "土曜プレミアムのワイルドスピード見たんだけど ヴィンディーゼルとドウェインジョンソンの筋肉凄すぎん?こんな体目指してるから筋トレ頑張ろうワイルドスピードドウェインジョンソンヴィンディーゼル https。
ヴィンディーゼル 2019最新版 身長や結婚、妻と子供、筋トレがすごい!画像あり。新作映画は?代表作はワイルドスピード – 海外ドラマ情報。
ヴィン・ディーゼルのトレーニング 筋トレWorkoutVin Diesel - YouTube。
ヴィンディーゼル ヴィン・ディーゼルの年齢身長出演作プロフィール&結婚や子供は?かっこいい。
映画『トリプルX:再起動』これぞヴィン・ディーゼル ヴィン史上極限のアクションが炸裂!! オフショット満載の特別映像が到着! -Astage-アステージ。
ワイルド・スピード』シリーズのヴィン・ディーゼル、元アシスタントに性的暴行で訴えられるカルチャーELLEエル デジタル。
ヴィン・ディーゼルの新作『リディック』、秋の撮影に向けて前進 - THR Japan。
ハリウッドスター 肉体改造,ヴィン・ディーゼル編Canaco Almendros。
ヴィン・ディーゼルの筋肉・体格が50歳を軽く超えた人とは思えないパワーラック完全ガイド。
Vin Diesel35歳から54歳の痩せ型男性がマッチョになる筋トレ方法。
イタすぎるセレブ達 『ワイルド・スピード』ドウェイン・ジョンソン、ヴィン・ディーゼルとの“確執の背景”明かすTechinsight テックインサイト 海外セレブ、国内エンタメのオンリーワンをお届けするニュースサイト。
Shirtless Vin Diesel flexes his grrr-eat muscles as he poses with fiercefeline companion。
筋肉俳優ヴィン・ディーゼル、 高画質の壁紙Pxfuel。
ついにヴィン・ディーゼルがドウェイン・ジョンソンに『ワイルド・スピード』シリーズ第10弾への復帰をインスタグラムで直接呼びかけた!!ジョンソンはどう答える?!– アクション・スター・ネットワーク。
Vin Diesel Prepares for FastX Part 2 Release。
新作予告編 ヴィン・ディーゼル『トリプルX』最新作、予告編&最新スチール写真! 4枚目の写真・画像Push on! Mycar-life。
ハリウッドスター 肉体改造,ヴィン・ディーゼル編Canaco Almendros。
ワイルド・スピード」ヴィン・ディーゼルの化身が肉フェス参戦 - 映画ナタリ。
ロック様とV・ディーゼルのリアルなバトルが勃発?SPICE - エンタメ特化型情報メディア スパイス。
不仲で共演NGのドウェイン・ジョンソン&ヴィン・ディーゼル、ついに雪解け!? ヴィンがドウェインにまさかのラブコール「『ワイスピ』のフィナーレに出てほしい」 - tvgroove。
ヴィン・ディーゼルと秘密の部屋で賢者のバーベルと謎のプリンセス』砂男 すなを。
質問です。ヴィン・ディーゼルのような体つきになるには筋トレをど- Yahoo!知恵袋。
ヴィン・ディーゼル演じるドミニク・トレット。 - 「ワイスピ」シリーズ歴代キャラ人気投票の結果発表、ぶっち切り1位は“あの男”画像ギャラリー2 7- 映画ナタリ。
ワイルド・スピード』ヴィン・ディーゼルとドウェイン・ジョンソンの再共演はあるか?監督が言及THE RIVER。
ヴィン・ディーゼル - 超人兵士のサンドバッグはコンクリの柱!?ブラッドショットNetflix Japan。
クリスマスを一緒に過ごすなら イケメンだらけで選べない!マーベル俳優をひたすら眺める 写真12点画像6 13最新の映画ニュースならMOVIE WALKER PRESS。